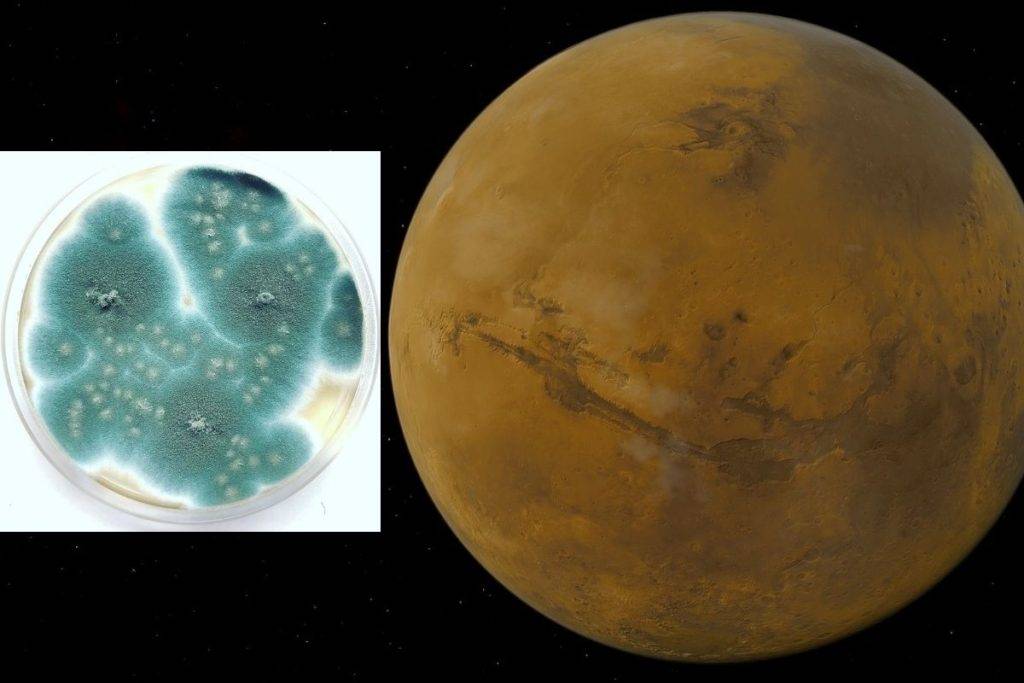
Microbios podrían sobrevivir temporalmente en Marte

Investigadores de la NASA y del Centro Aeroespacial Alemán enviaron microbios a la atmósfera terrestre; ahí, las condiciones son muy similares a las del planeta rojo

Regeneración 22 febrero 2021. Un equipo de científicos comprobó que algunas formas de vida de la Tierra pueden sobrevivir temporalmente en Marte.
Investigadores de la NASA y del Centro Aeroespacial Alemán enviaron microbios a la atmósfera terrestre; ahí las condiciones son muy similares a las del planeta rojo.
También, con ello se probó la resistencia de algunos microbios en una sonda que se envió a la estratósfera de la Tierra con el objetivo de estudiar su potencial; además de las posibles amenazas de los viajes tripulados a Marte.
Los científicos expusieron, en un globo científico, bacterias y hongos a unas condiciones similares a las de Marte; comprobaron cómo algunos pudieron sobrevivir al viaje.
Incluso, algunos se expusieron a radiación ultravioleta muy elevada.
La investigadora Marta Filipa Cortesão, del Centro Aeroespacial Alemán, dijo que comprender la resistencia de los microbios a los viajes espaciales es vital para el éxito de futuras misiones.
“Con misiones tripuladas a largo plazo a Marte, necesitamos saber cómo sobrevivirían los microorganismos asociados con los humanos, ya que algunos pueden representar un riesgo para la salud de los astronautas”, explicó la investigadora Katharina Siems.
Muchas características del medio ambiente de la superficie marciana no se pueden replicar fácilmente en la superficie de la Tierra.
Sin embargo, por encima de la capa de ozono esas condiciones son notablemente similares.
Experimento
Los investigadores lanzaron a la estratosfera los microbios dentro de una caja (MarsBox) que se mantuvo a “presión marciana” y se llenó con atmósfera marciana artificial.
Dentro de ella se diferenciaron dos capas; una protegida de la radiación y otra sobreexpuesta a la radiación.
Con ello se comprobó que no todos los microbios sobrevivieron al viaje; uno de ellos, el moho negro revivió al regresar a la Tierra.
Finalmente, este trabajó se publicó en la revista Frontiers un Microbiology y subrayó que los microorganismos están estrechamente conectados con los humanos, con su cuerpo, la comida etc, por lo que es imposible descartarlos en los viajes espaciales.
Life from Earth could temporarily survive on Mars @frontiersin @frontiersin https://t.co/W7XbAng2Ft
— Phys.org (@physorg_com) February 22, 2021